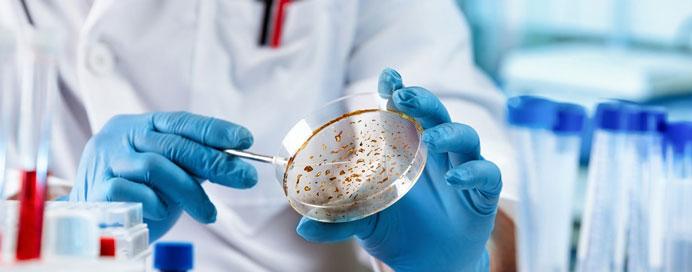

Infectious Diseases
Infectious Diseases focuses on the prevention, diagnosis, and treatment of illnesses caused by bacteria, viruses, fungi, and parasites. These diseases can spread through air, water, food, or direct contact, making early detection and proper management essential. Specialists in this field use advanced diagnostic methods and targeted therapies to control infections, reduce complications, and prevent outbreaks. From common infections like flu to serious conditions such as COVID-19, infectious disease care plays a critical role in safeguarding public health.
Importance of Infectious Disease Care
Effective infectious disease care is crucial for controlling the spread of infections and protecting individuals and communities. Early diagnosis and timely treatment not only improve recovery but also help prevent transmission to others.
